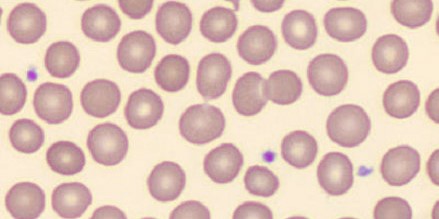

This post was written by Leslie Chaparro, MLS(ASCP)CM SHCMCM, hematology specialist, Parkview Health.
When you have blood work done, it's easy to imagine the process ending with a machine producing results on a computer screen. But behind every result is a team of highly trained laboratory professionals using advanced technology and their own expertise to carefully review and interpret your blood cells.
One tool that helps our laboratory provide fast, reliable and high-quality results is CellaVision®, a digital imaging system that enhances the way we examine blood cells.
What Is CellaVision?
CellaVision is a digital microscopy system used by hematology laboratories to examine blood smears. Instead of viewing cells only through a traditional microscope, the system captures high-resolution images of blood cells and displays them on a secure computer screen.
This allows laboratory professionals to:
-
View blood cells in greater detail
-
Identify abnormal or immature cells more easily
-
Share and review images with colleagues or a pathologist for consultation.
Most importantly, it supports consistent, accurate results for every patient.
Why looking at blood cells matters
Your blood contains several types of cells, each with a unique and essential function:
-
Red blood cells carry oxygen
-
White blood cells help fight infection
-
Platelets help stop bleeding
Changes in the appearance or number of these cells can give important clues about:
-
Infections
-
Increased white blood cells
-
Shifts in the distribution of white blood cell types
-
-
-
Small, pale red cells are seen in iron deficiency anemia
-
Abnormally shaped red cells can be seen in some types of hereditary anemias like sickle cell anemia
-
-
How well treatments are working
CellaVision helps ensure these details are not overlooked, even when these changes are subtle. Check out these examples of common blood smear findings:
Normal blood smear. This is a microscopic image of blood from a healthy individual. The pink circles with a lighter center are red blood cells. These cells carry oxygen throughout your body. The lighter spot in the middle is because the cells are disc-shaped and have a thinner center resembling a soft, squishy donut without a hole.
Normal blood smear. This is a microscopic image of blood from a healthy individual. The pink circles with a lighter center are red blood cells. These cells carry oxygen throughout your body. The lighter spot in the middle is because the cells are disc-shaped and have a thinner center resembling a soft, squishy donut without a hole.
This allows them to bend and squeeze through the smallest blood vessels throughout your body to deliver oxygen to all the tissues. The tiny purple specks are platelets (PLT). These are tiny pieces of cells that are always floating along in the blood, looking for distress signals from injured blood vessels. They rush to the injury, stick to it like a magnet and signal other platelets to help. As more platelets stick together, they form a soft plug to seal up the damage and stop the bleeding.
 Abnormal blood smear. These red blood cells are paler because they carry less oxygen than they should. They are also showing more differences in size and shape than the normal image. This can be a sign of anemia, and a doctor may order additional tests to determine the cause. The dark purple-blue cell you see is a type of white blood cell called a lymphocyte, which is part of your immune system.
Abnormal blood smear. These red blood cells are paler because they carry less oxygen than they should. They are also showing more differences in size and shape than the normal image. This can be a sign of anemia, and a doctor may order additional tests to determine the cause. The dark purple-blue cell you see is a type of white blood cell called a lymphocyte, which is part of your immune system.
White blood cell types. White blood cells come in different types, and each one has its own special job in protecting the body. They work together to fight infections, heal injuries, and respond to different illnesses. Kind of like a little army circulating in your veins. There are five main types of white blood cells that are always present but in different numbers depending on age, health status, and other factors:
-
Neutrophils are the first responders; they rush to sites of infection, especially bacterial infections, and help clean things up.
-
Lymphocytes are the planners and memory keepers; they help your body recognize germs and remember them so you can fight them off next time.
-
Monocytes are the clean-up crew. They turn into larger cells that "eat" germs, dead cells and debris.
-
Eosinophils are the allergy and parasite fighters that help your body react to allergies and fight infections of parasites.
-
Basophils are the chemical releasers that help start inflammation, especially during allergic reactions, to signal more help from the other white blood cells.

Technology that complements human expertise
In one of our highest-volume hematology labs, more than 1,000 samples are processed every day. While instruments perform the initial analysis, laboratory scientists play a critical role in evaluating results that fall outside the normal range or appear suspicious due to interferences.
Since 70% of all medical decisions are based on laboratory results, a thorough and accurate review is essential. You may never see this technology, but its impact is reflected in the quality of care you receive. Tools like CellaVision offer:
More detailed and consistent reviews. Digital imaging allows lab scientists to review cells side-by-side and revisit images when needed, reducing variability and improving accuracy.
-
What this means for patients: Your results are based on careful, thorough review—not rushed decisions.
Faster answers when time matters. CellaVision quickly captures and organizes images within minutes, allowing the laboratory scientist to evaluate urgent samples more efficiently.
-
What this means for patients: In emergency or critical situations, important results can be shared with providers sooner, supporting timely care.
Team-based expertise. Images can be securely shared with the lead scientist, pathologists, or specialty providers for second opinions or confirmations when needed.
-
What this means for patients: More than one set of trained eyes may review a sample—an extra layer of safety and quality.
Supporting complex diagnoses. Some blood conditions involve very subtle changes that can be hard to spot. High‑quality digital images help lab specialists recognize rare or unusual cells that could point to more serious conditions.
-
What this means for patients: Earlier recognition may lead to quicker follow‑up testing and more targeted treatment.
Final thoughts
Exceptional care doesn’t stop at the bedside. It continues in the lab, where skilled professionals use advanced technology to ensure your test results are accurate, timely, and trustworthy.
By combining expert laboratory staff with tools like CellaVision, our hematology lab is committed to supporting your health one carefully reviewed blood cell at a time.
To learn more about Parkview's laboratory services, visit us here.




